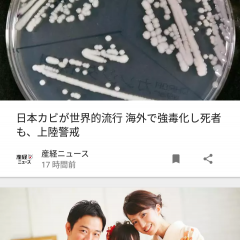
便利に使える、ニュースアプリの後読み機能のサムネイル

編集部のおすすめポイント
音声読み上げ機能で記事を「聞く」ことも出来る
一旦保存すれば圏外でもWifiがなくても別デバイスでも記事が読める
自分のお気に入り記事を友達やフォロワーにおすすめ出来る機能
Pocketのスクリーンショット
App Storeより引用





Pocketとは?
保存した記事はオフライン上で読む事が出来て制限もなし!気になる記事はどんどん保存して読みまくれる!!
「Pocket」というアプリは、気になる記事や面白い記事を保存したいと思った時、スクリーンショットでもブックマークでもなく「Pocket」による保存をして後でオフラインであっても場所も時間も問わず、更に同期機能によりiPhone以外のパソコンなどでも読める事が出来る最高に便利なアプリです。Pocketは読みやすさ、使いやすさ、そして使用シーンなどあらゆる場面において優秀で、デザインなどのカスタマイズや自分好みのおすすめを見つけられるなどの付加機能も充実!記事の保存に関して優秀なアプリを探しているなら「Pocket」を使ってみるのがおすすめです!
Pocketの特徴・編集部レビュー
興味のあるニュースや記事を保存しておけばネット接続無しでもいつでもまとめて読めるアプリ
poketは、googleやブログ、SNSなどで見かけた気になる記事を簡単な操作で保存しておいてあとで読むことができる無料のアプリ。対応しているwebサービスやアプリが多いので、豊富な情報源から選んで保存しておくことができます。保存された記事は最低限のテキストと画像のみのPoketオリジナル画面に表示されます。このためネット接続無しでも記事を読むことが可能。保存した記事はSNSでシェアするなど色々な楽しみ方ができます。
メリット:対応しているwebサービスやアプリが豊富なため、様々な情報源から記事をまとめて保存することが可能。保存した記事はネット接続無しでも読むことができます。
デメリット:保存した記事の細かいジャンル分けなどの整理ができないので長期保存に向きません。読んだ記事はSNSでシェアするなどアウトプットしておくのがおすすめです。
ユーザーのレビュー
-
ハンズフリーで情報入手できる
読み上げ機能がついてるので、家事をしながら好きな情報を得れて助かります!
ホヨノ 2019年6月28日 -
多数のデバイスに対応している点がウリ
ニュースを見られるのですが、多数のSNSと連携できる点が最大の魅力だと思います。よく自分はTwitterを使うのでそのままニュースを見られてとても便利です。
どー 2019年6月28日 -
記事を読んでくれる
記事を読むのが面倒な人に便利です。これがあると読み上げてくれます。
陽太 2019年6月18日
「Pocket」スペック・仕様
- 開発者
- Read It Later, Inc
- リリース
- 2009年4月9日
- サイズ
- 165.57 MB
- 価格
- 無料
- カテゴリ
- 趣味・エンタメ コンピューター・IT インターネット
- ダウンロード